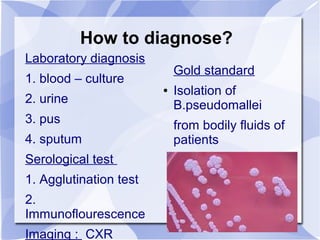
How to diagnose? 
Laboratory diagnosis 
1. blood – culture 
2. urine 
3. pus 
4. sputum 
Serological test 
1. Agglutination test 
2. 
Immunoflourescence 
Imaging : CXR 
Gold standard 
● Isolation of 
B.pseudomallei 
from bodily fluids of 
patients

Melioidosis is an infectious disease caused by the bacterium Burkholderia pseudomallei, commonly found in soil and water in Southeast Asia and northern Australia. It most often infects the lungs and symptoms are non-specific, including fever. It is diagnosed through culturing the bacteria from blood, urine, sputum or skin lesions. Treatment involves long-term antibiotics such as ceftazidime and co-trimoxazole, with an overall mortality rate of 50-70% even with treatment.